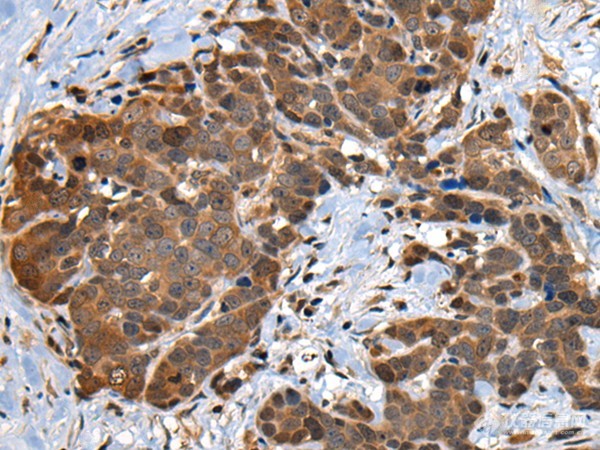
rabbit polyclonal antibody 别名:cdc28 protein kinase regulatory

anti regulatory

anti-protein phosphatase 4, regulatory subunit 2 (ppp4r2)
图片尺寸610x410
rabbit polyclonal antibody 别名:cdc28 protein kinase regulatory
图片尺寸600x450
image for anti-regulatory associated protein of mtor, complex 1
图片尺寸810x610
anti-kh-type splicing regulatory protein (khsrp) (middle region)
图片尺寸610x410
image for anti-sirpa 抗体 (signal-regulatory protein alpha) (ab
图片尺寸810x610
blotting (wb) image for anti-protein phosphatase 1, regulatory
图片尺寸810x610
anti-cd46 molecule, complement regulatory protein (cd46) (aa 1
图片尺寸610x410
anti-protein phosphatase 2, regulatory subunit b, gamma (ppp2r
图片尺寸810x610
an antiangiogenic neurokinin-b/thromboxane a2 regulatory axis
图片尺寸801x1134
英文研究报告 文章正文antitrust policies centered on promoting
图片尺寸863x560
anti-cd46 molecule, complement regulatory protein (cd46) (aa 1
图片尺寸610x410
hsp60 as a target of anti-ergotypic regulatory t cells
图片尺寸1368x902
anti-interferon regulatory factor 4 (irf4) antibody
图片尺寸810x610
on up to four sites in response to many regulatory signals
图片尺寸546x464
proteins and cancer: an update from functional and regulatory
图片尺寸689x694
cgtn每日打卡day4
图片尺寸1080x1323
regulatory cd8cells induced with anti-cd3 antibody
图片尺寸1427x2049
image for anti-cd46 molecule, complement regulatory protein (cd
图片尺寸810x610
phosphatase 2a activator, regulatory subunit 4 (ppp2r4) antibody
图片尺寸810x610
docosahexaenoic acid reduces sterol regulatory element binding
图片尺寸567x578

-0.5ug-placenta.jpg)












